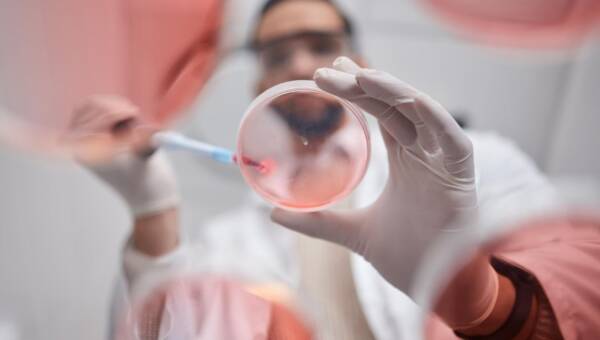
naukowiec bada komórkę

Poradnik zdrowie - zdrowy styl życia

Jak jeść zimą, by nie przytyć i mieć energię?

Mrożenie komórek jajowych – moda czy konieczność?

Zdrowa dieta podczas świąt – drobne zmiany, które warto wprowadzić

Fizjoterapeuta radzi: 5 sposobów na zdrowy kręgosłup

Fitness umysłu – czyli jak wzmocnić najważniejszy z mięśni!

Zimowy sposób na rozgrzewkę i szczupłą sylwetkę, czyli gotujmy zupy!

Wiktor Morgulec opowiada o tajnikach jogi

Ksylitol cukier brzozowy – zdrowa alternatywa dla białego cukru

Zespół policystycznych jajników – objawy i leczenie

Dietetyk o hitach roku: czy naprawdę działają?

Jak przyspieszyć metabolizm w okresie zimowym

Ekspert wyjaśnia: Uzależnienie od słodyczy – jak się od niego uwolnić?

Powiększenie piersi przy użyciu komórek macierzystych

Sposoby naszych mam na odporność

Jak uniknąć zbyt wielu kalorii podczas świąt?

Dr L. Pachocka dietetyk z Instytutu Żywności wyjaśnia: Tłuszcze trans – co to takiego?

A. Piskała – spec. ds. żywienia wyjaśnia: Jakie jeść ryby i jak je przygotowywać

Niepłodność to nie wyrok

Otyłość, cukrzyca, dna moczanowa, choroby tarczycy – jak zdiagnozować te choroby?

Jedzenie, którego nie powinno się trzymać w lodówce

Lecznicze właściwości ostropestu plamistego. Czy je znasz?

Jak rozmawiać z ginekologiem o antykoncepcji hormonalnej?

Jak wyuczyć mózg zdrowego żywienia?

Co to znaczy żywność ekologiczna?

Czy solaria w Polsce powinny byc zakazane?

Książka kucharska „Koniec z cukrzycą i otyłością” – już w księgarniach

Dzisiaj Dzień Wcześniaka – jakie szanse mają wcześniaki dzięki współczesnej medycyjnie?

Czy wiesz, jakie są zdrowe suszone śliwki?

Lekarz podpowiada: Sprawdzone domowe sposoby na katar niemowlaka